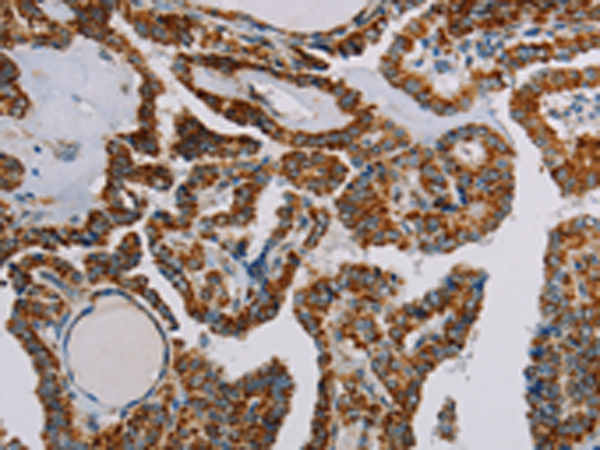
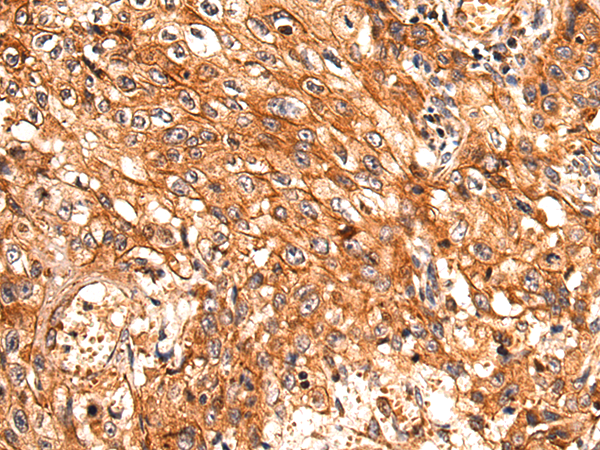
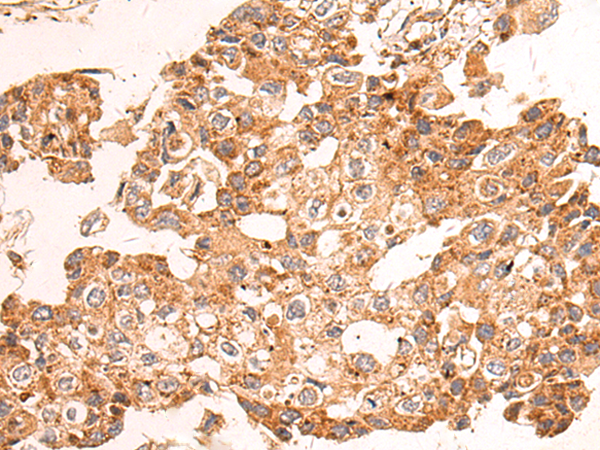

-
分类: 科研抗体货号: P01588别名: UQOR1; CI-51K; CI51KD应用: WB反应种属: Human, Mouse
-
分类: 科研抗体货号: P01531别名: MORG1应用: WB,IHC反应种属: Human, Mouse, Rat
-
分类: 科研抗体货号: P01583别名: CI-30应用: WB,IHC反应种属: Human, Mouse
-
分类: 科研抗体货号: P01611别名:应用: WB反应种属: Human
-
分类: 科研抗体货号: P01580别名: B8; CD14; CIB8; MC1DN13应用: WB,IHC反应种属: Human, Mouse
-
分类: 科研抗体货号: P01607别名: S171; C14orf41; c14_5527应用: WB反应种属: Human, Mouse, Rat
-
分类: 科研抗体货号: P01577别名: CGI65; CIA30; CGI-65应用: WB反应种属: Human, Mouse
-
分类: 科研抗体货号: P01606别名: NS; E2IG3; NNP47; C77032应用: WB,IHC反应种属: Human
-
分类: 科研抗体货号: P01655别名: MPPB; P-52; MPP11; MPPP52; Beta-MPP应用: WB,IHC反应种属: Human, Mouse, Rat
-
分类: 科研抗体货号: P01604别名: CN1; CNI; CN-I; CN1A; CN-IA应用: IHC反应种属: Human, Mouse

鄂公网安备42018502007531号
鄂公网安备42018502007531号

